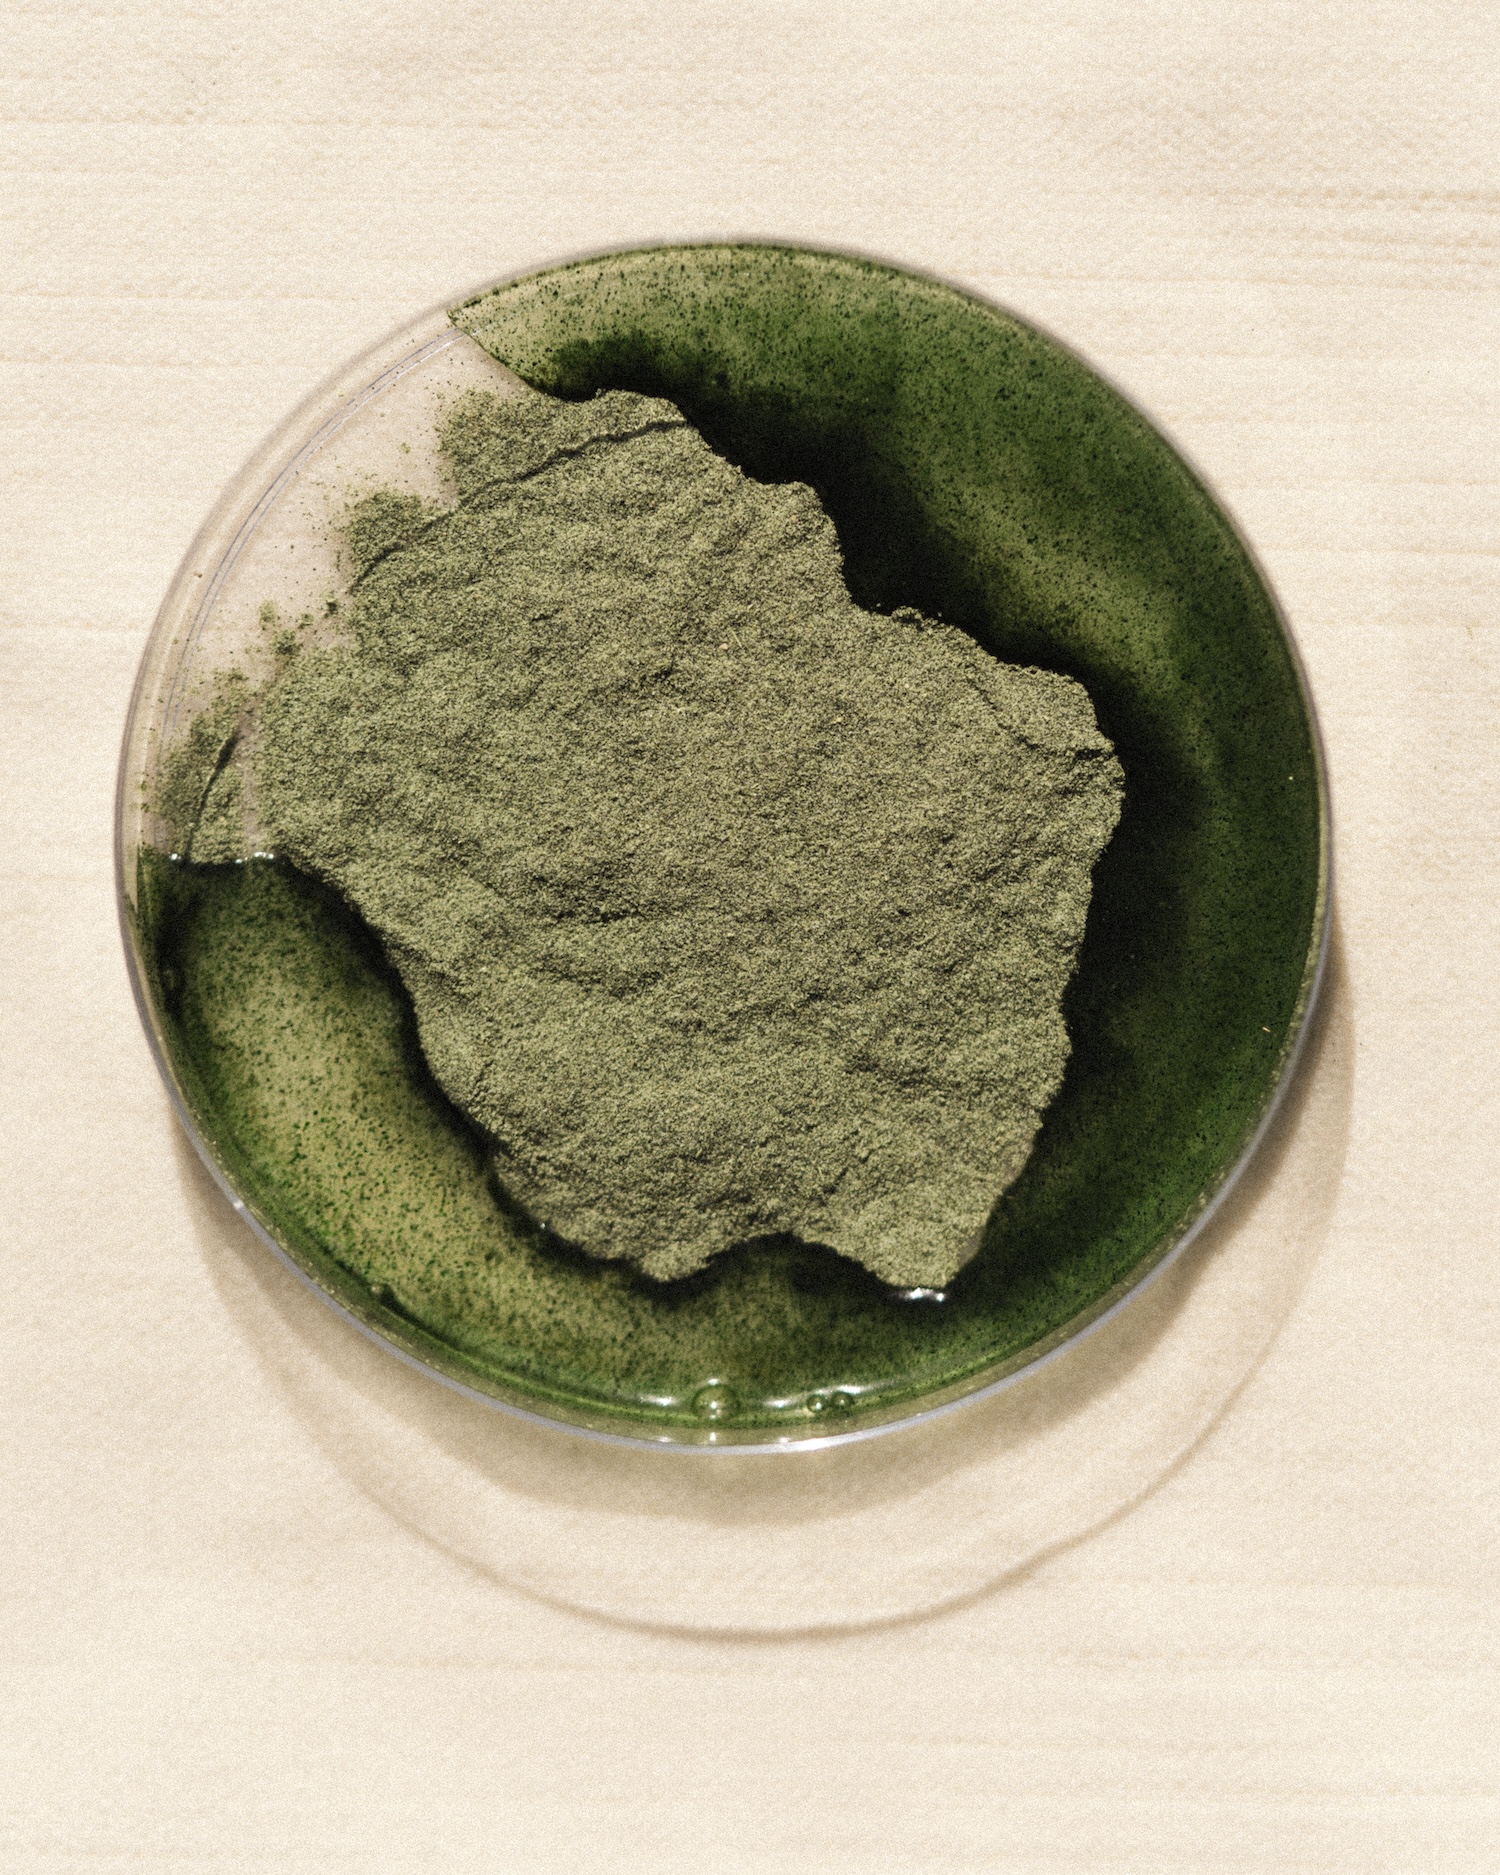

axia

axia

axia

axia
axia

axia

axia

axia

axia

axia
axia
Your invested creative partner for launching and accelerating brands.



























ONGOING CREATIVE
Integrated creative support for growth-stage brands.
Creative direction
Social content + performance creative
Paid ad design
Email marketing strategy + design
Launch campaigns + production
Social media graphics
UGC asset creation
Web design + maintenance

Brand Launches
Foundational creative for brands just launching or reinventing.
Creative direction
Brand identity systems
Naming + positioning
Packaging design
Website design + development
Launch campaign + asset library
Photography + videography
Timeline: 6-12 weeks
Studio Projects
A la carte, high-impact creative tailored to a unique need.
Full-scope production
Photography + videography production
Packaging + retail design
Campaign creative
Pitch decks or investor materials
Website + landing page design


Venture Partnership
Creative-first incubator for founders seeking long-term partnerships.
We partner with founders we believe in and align with, acting as embedded partners and investing our services for equity. We unlock the collective strength of strategy and creative to shape brands from the ground up, support go-to-market strategy, and drive future growth efforts.
Typically involved between Seed and Series A, we help startups secure further investment, accelerate growth, and build enduring brands.
ONGOING CREATIVE
Integrated creative support for growth-stage brands.
Creative direction
Social content + performance creative
Paid ad design
Email marketing strategy + design
Launch campaigns + production
Social media graphics
UGC asset creation
Web design + maintenance

Brand Launches
Foundational creative for brands just launching or reinventing.
Creative direction
Brand identity systems
Naming + positioning
Packaging design
Website design + development
Launch campaign + asset library
Photography + videography
Timeline: 6-12 weeks
Studio Projects
A la carte, high-impact creative tailored to a unique need.
Full-scope production
Photography + videography production
Packaging + retail design
Campaign creative
Pitch decks or investor materials
Website + landing page design

Venture Partnership
Creative-first incubator for founders seeking long-term partnerships.
We partner with founders we believe in and align with, acting as embedded partners and investing our services for equity. We unlock the collective strength of strategy and creative to shape brands from the ground up, support go-to-market strategy, and drive future growth efforts.
Typically involved between Seed and Series A, we help startups secure further investment, accelerate growth, and build enduring brands.